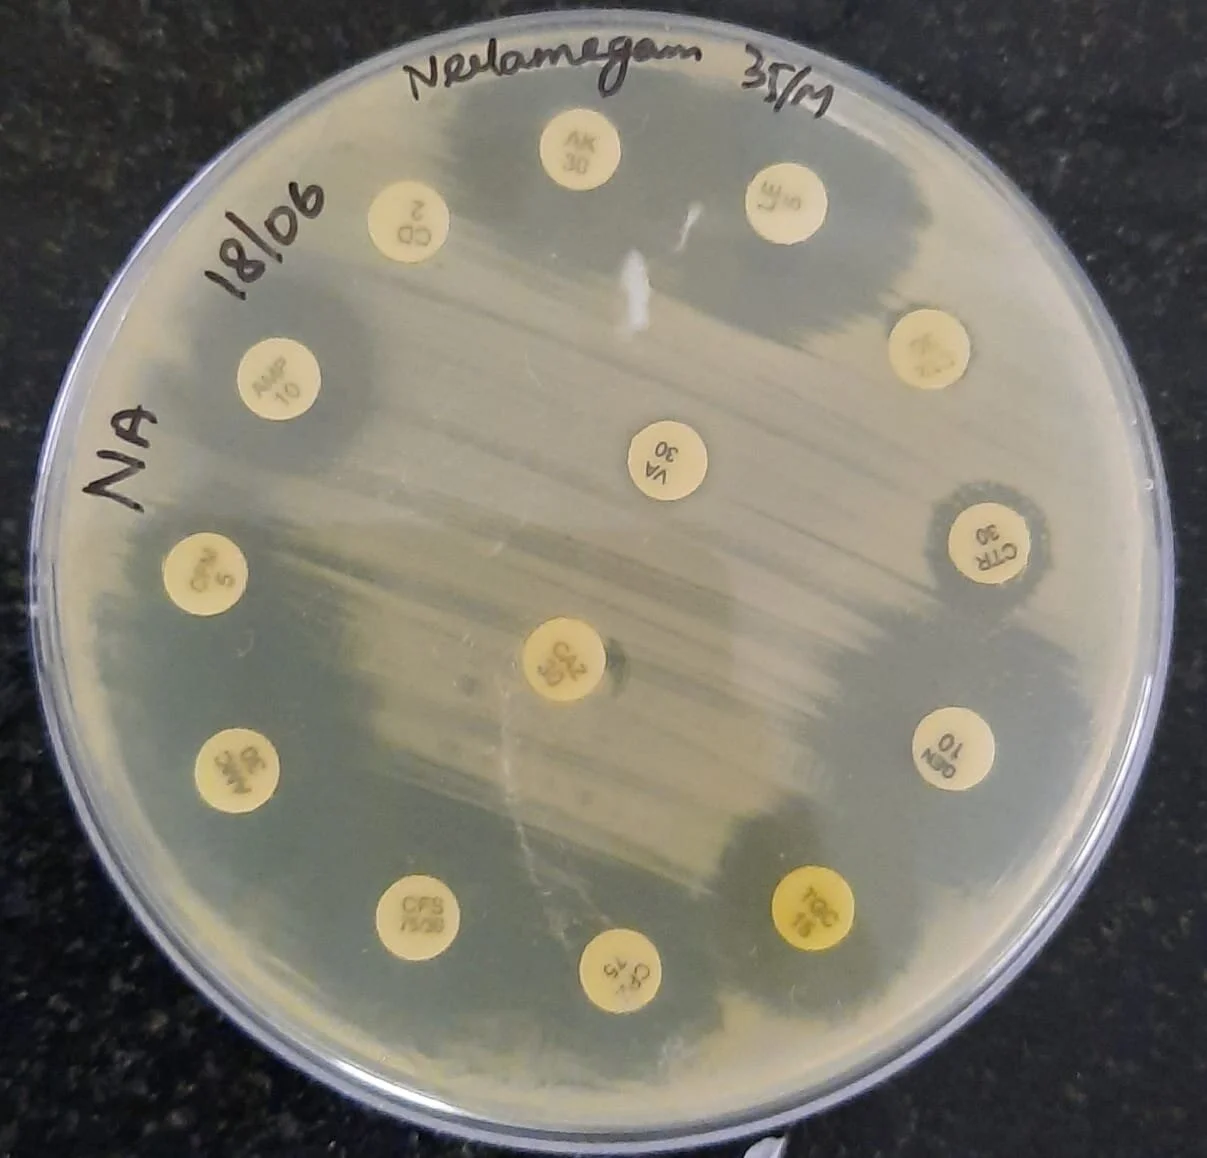
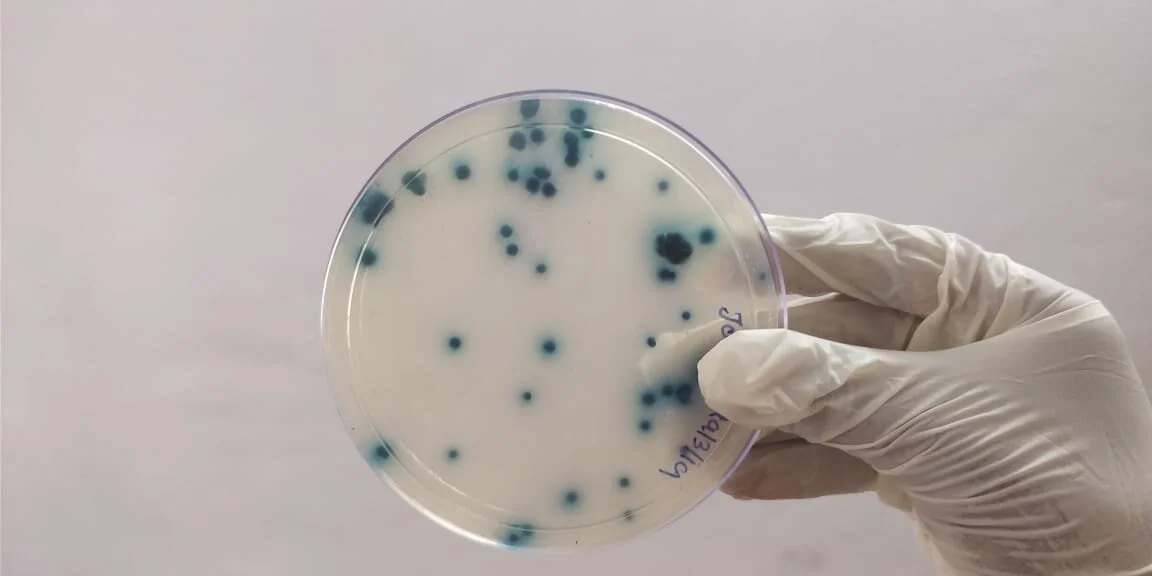

DIAGNOSTIC LABORATORY SERVICES
Our department has a fully equipped diagnostic service laboratory. It caters to the needs of the dental hospitals and the general hospital. We provide cost-effective advanced diagnostic services for patients visiting the hospital for treatment. The laboratory is manned by experienced and qualified technicians, working under the supervision of the faculties of the department. The laboratory has facilities to do routine microbiological investigations and advanced procedures. At the time of need, we take up the survey and recommend a protocol for clean hygienic practices in the hospital campus. We do sterility checks for the operation theatre on a routine basis. We extend our diagnostic services to other hospitals as well as academic institutions also. When necessary we carry out screening programs/investigate outbreaks.
PHENOTYPIC CHARACTERIZATION OF BACTERIAL PATHOGENS
ANTIMICROBIAL RESISTANCE STUDIES
MYCOLOGY RESEARCH STUDIES
QUALITY CONTROL SERVICES - WATER ANALYSIS
PHYCOTECHNOLOGY LAB
CONSULTANCY SERVICES & INDUSTRIAL VISITS
The microbiology department is one of the reference centers for the city colleges to carry our research projects. They reach us for guidance and to design the research projects. Industrial visits from city colleges are also under progress, where they undergo training in advanced molecular microbiology methodologies. We provide guidance for designing projects and help them carry out their dissertation work.